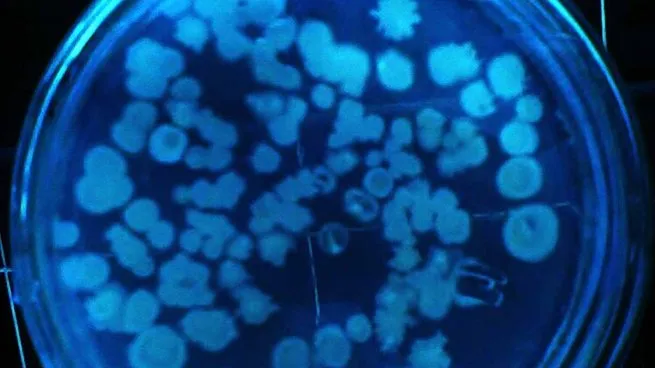
bacteriasjpg

La Justicia decidió qué pasa con los trabajadores que son obligados a cambiar de turno
El tribunal entendió que pasar de un turno diurno a uno nocturno impacta en la vida personal, familiar y en la seguridad del trabajador.
Profesionales de la salud alertaron sobre el uso indebido de los antibióticos y su consecuente resistencia en el organismo. "Se debe intensificar la búsqueda de nuevos antibióticos y usarlos de manera consciente", señalan.
PAÍS19/11/2024 19640 Noticias
19640 Noticias
La muerte por infección de bacterias resistentes van a superar a las muertes por cáncer, según una proyección de la Organización Mundial de la Salud (OMS) para 2050. Profesionales de la Facultad de Farmacia y Bioquímica de la UBA hicieron referencia a este tema, que representa una amenaza actual.
Este tema amenaza a largo plazo sobre la salud humana y animal, la producción de alimentos y el desarrollo mundial. Los antibióticos son fármacos que se utilizan en la comunidad desde en 1928, con un boom entre los años 50 y 60 en los cuales se descubrieron la mayoría de los antibióticos que se usan hoy en día.
Pablo Power, profesor adjunto de Microbiología en la FFyB e investigador independiente del CONICET sostuvo que esta proyección de la OMS es por "infecciones producidas por bacterias resistentes a antibióticos" y van a equiparar a las muertes "por distintos tipos de cáncer".
Muertes por bacterias resistentes: ¿qué más se sabe?
Esta problemática se acrecentó durante la pandemia de COVID, lo que comprometió aún más la efectividad de los antibióticos. Casi un 90 % de los pacientes internados fueron tratados con antibióticos debido a las infecciones bacterianas asociadas y esta situación manifiesta lo amenazante que resulta la resistencia a los antimicrobianos.
“Lo que hizo la pandemia de covid fue acelerar esos tiempos lamentablemente entonces ahora lo que se proyectaba para el 2050 se estima que se va a adelantar quizás para el 2030. Se hizo un abuso de antibióticos en los centros de salud que disparó gran cantidad de mecanismos de resistencia”, sostuvo Power.
¿Por qué hay resistencia a los antibióticos?
La resistencia a los antibióticos se disparó por un uso innecesario. Power detalla que "en muchos casos virales, el paciente se va a curar sin antibióticos en la misma cantidad de tiempo porque las infecciones virales no funcionan con antibióticos", ya que depende del tipo de infección.
“Pretendemos que se nos venda el medicamento que nosotros queremos y no el que nos receta el médico o el que nos indica el farmacéutico. Nos encontramos con pacientes que piden que les vendan tal antibiótico y ahí entra la cuota de responsabilidad que tenemos los profesionales de la salud", detalla Power en casos como en los que se les debe indicar al paciente que no se puede vender un antibiótico sin receta.
Estudiar la resistencia a los antibióticos, una deuda pendiente
Entonces resulta urgente estudiar las formas en que las bacterias desarrollan esta resistencia a los antibióticos, para alertar y ayudar en el diseño de nuevas drogas eficaces. En el mismo sentido es fundamental la capacitación de todo el personal de salud, estar al día con los antibióticos disponibles y las dosificaciones debidas.
Para finalizar Power indicó : “Se debe intensificar la búsqueda de nuevos antibióticos ya que nada va a ser más efectivo para tratar enfermedades infecciosas. Debemos cuidarlos y usarlos de manera consciente y cuando corresponde en las dosis adecuadas".

El tribunal entendió que pasar de un turno diurno a uno nocturno impacta en la vida personal, familiar y en la seguridad del trabajador.

El país movilizó casi 16 mil toneladas en septiembre y se ubicó entre los cuatro mercados con mayores subas de la región, según datos de ALTA.

La jornada cambiaria terminó con el dólar blue y el oficial en valores estables. Estas fueron las cotizaciones de compra y venta que marcaron el cierre del día.

Nuevas herramientas digitales, monitoreo remoto e inteligencia artificial permiten reducir complicaciones y anticipar emergencias en bebés prematuros.

La pensión universal equivale al 80% de una jubilación mínima y, se actualiza por movilidad. Se puede tramitar las 24 horas.

Incluye una subvención económica equivalente a tres salarios mínimos vitales y móviles. La iniciativa fue presentada por Eduardo Valdés (UxP).

La Resolución 489/2025 modifica el proceso productivo de celulares en Tierra del Fuego, reduciendo requisitos e introduciendo un esquema más flexible que divide opiniones entre empresarios y sindicatos.

Dos personas fueron encontradas sin vida en distintas ciudades de Tierra del Fuego. En ambos casos, las pericias descartaron la intervención de terceros y continúan las actuaciones de rigor.